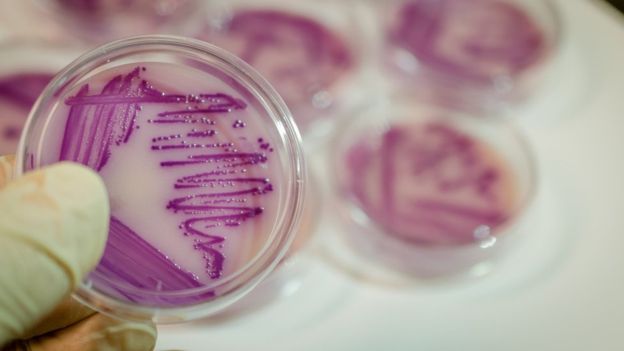

Algunas investigaciones recientes de la Universidad de Mauricio, tienen malas noticias para los usuarios frecuentes de pañitos de cocina. Pues estos son acorazados de monstruos microbianos invasores. Gracias en parte a la frecuencia con la que se reutilizan, a menudo son láminas con incrustaciones de inmundicia infestadas de bacterias, lo que significa que te están poniendo a ti, un inocente habitante de la cocina, en un riesgo elevado de intoxicación alimentaria.
Dicho esto, probablemente no todos de repente comencemos a prender fuego a nuestras cocinas para evitar que Escherichia coli entre en nuestras tripas y provoque deposiciones profusas.
Si bien es cierto que un nuevo estudio encontró que los pañitos de cocina no son exactamente bastiones de limpieza, no necesariamente es necesario desterrarlas para siempre a los pozos más profundos y oscuros del infierno.
Contenidos de esta página
Los pañitos de cocina podrían cultivar bacterias y virus a montón
Todavía no se encuentra disponible para la revisión por pares, se presentó por primera vez la semana pasada en la reunión anual de la Sociedad Americana de Microbiología en Atlanta, en Georgia. El equipo recolectó 100 pañitos de cocina, versiones de un solo uso y de usos múltiples. Luego de un mes de uso de una variedad de hogares, y luego cultivó las bacterias en ellas para identificar cepas y cargas bacterianas.
Descubrieron que el 49 por ciento de ellos tenía crecimiento bacteriano. Las toallas de familias más grandes, particularmente aquellas con niños o una familia extensa, estaban más infestadas. Las toallas multiusos tenían un conteo bacteriano más alto que las toallas de un solo uso. La humedad en el hogar aumentó las cargas bacterianas.
Las cepas bacterianas comunes fueron E. coli, especies que pertenecen al género Enterococcus y Staphylococcus aureus.
Un poco sobre eso. S. aureus comúnmente coloniza la piel y los revestimientos de la mucosa sin incidentes, pero a veces puede causar infecciones si se pone debajo de la piel. Las bacterias enterococos, que a menudo se encuentran en las heces de humanos y animales, a veces pueden infectar heridas o causar infecciones del tracto urinario.
E. coli es más famoso por causar los síntomas de intoxicación alimentaria, pero vale la pena señalar que la mayoría de las cepas de E. coli son completamente inofensivas para nosotros. Tanto E. coli como S. aureus fueron mucho más prevalentes en toallas en familias con dietas no vegetarianas, siendo esta última más comúnmente aislada de familias con niños o con un estatus socioeconómico más bajo.
El consejo para evitar usar pañitos de cocina con usos múltiples
El consejo de los autores, entonces, es abstenerse de usar pañitos de cocina de usos múltiples, para mantener las toallas fuera de los ambientes húmedos, y para estar especialmente atentos si tiene familiares extendidos o si tiene niños.
Si se pregunta qué tan enloquecido debería estar al respecto, nos registramos con el Dr. Ben Libberton, microbiólogo del Laboratorio MAX IV en Lund, Suecia, que no participó en el estudio. Tras señalar que estos resultados no fueron particularmente sorprendentes. Explicó que cualquier cosa que se moje y se contamine con alimentos viejos tiene un riesgo similar.
«Pasa lo mismo con las esponjas. Son un caldo de cultivo para las bacterias, y las usamos en nuestras placas limpias», dijo a IFLScience. Además, es probable que ayudes a las bacterias a acumular «cualquier cosa que tenga grietas que no puedan desinfectarse fácilmente, como las tablas de cortar». El orificio del tapón puede ser una pesadilla si también le quedan alimentos.
Entonces, ¿estamos todos condenados por nuestras cocinas?
«Quiero decir, estamos bien, ¿no? O las enfermedades no son tan graves, no suceden o no se informan lo suficiente», explicó Libberton. Agregó que tener una cocina sucia seguramente aumentará sus probabilidades de enfermarse. Por lo que, si ese es el caso, la solución es clara: lave las cosas con más frecuencia, incluso sus manos.
Fuente: iflscience
Recomendaciones similares:
